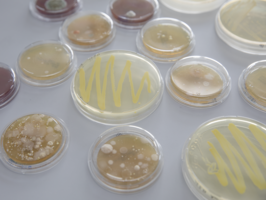

Personalisierter Fortschritt

Die Forschung im Labor Molekulare Biomedizin leistet einen wichtigen Beitrag für Innovationen und technologischen Fortschritte in der personalisierten Medizin. Zellkulturexperimente und Genanalysen tragen zur Entwicklung neuer Diagnosetools und Behandlungsmethoden bei.
Das Labor Molekulare Biomedizin steht zum einen für die Lehre im höheren Semester zur Verfügung. Zum anderen arbeiten hier auch Thesis-Studierende, DoktorandInnen und Post-Docs an innovativen Projekten. Das Labor erfüllt Sicherheitsstufe 1 für risikolose gentechnische Experimente und hat einen S2 Bereich für die Arbeit mit Mikroorganismen der Risikogruppe 2.
Hier entsteht Zukunft: innovative Forschung und praxisnahe Ausbildung in einer dynamischen und hochmodernen Umgebung.
Bilder 1, 2: © Hochschule Furtwangen/ Bernd Müller.
Bilder 3, 4, 5, 6: © Hochschule Furtwangen/ Silicya Roth
Laborfunktionen
- Isolierung und Analyse von Mikroorganismen aus menschlichen und tierischen Proben etwa durch Kultivierung, MALDI-Biotyping und (Next Generation) Sequenzierungen.
- Zellkulturexperimente und verschiedene Genexpressionanalysen, u.A. mittels real-time PCR (qPCR)
- Gentechnische Arbeiten (S1) mit Zellkulturen
- Arbeit mit Mikroorganismen (Risikogruppe 2) unter S2 Bedingungen
- Fluoreszenz-in-situ-Hybridisierungen (FISH)
- Sequenzierungen von kleineren Genomen, Amplikons und smallRNAs (Next generation sequencing / Third generation sequencing)
- 16S Metagenomik- & Shotgun-Sequencing
- Quantifizierungen und Detektion von Proteinen
- Forschung an Nanopartikeln
Ausstattung & Geräte
Neben der gängigen Laborausstattung in den Bereichen Zellkultur, Mikrobiologie, Molekularbiologie und teilweise Biochemie, finden sich im Labor einige Geräte, die neben der Anwendung in der Forschung auch in der Diagnostik eingesetzt werden.
MALDI-Biotyper
Eine Methode zur Identifizierung von Mikroorganismen, die mithilfe der MALDI-TOF Massenspektrometrie das Proteinspektrum einer Probe analysiert und es mit einer Datenbank bekannter Spektren vergleicht. Dadurch können Bakterien und Pilze schnell und präzise bis auf die Speziesebene identifiziert werden.
MiSeq
Das MiSeq-System von Illumina ist ein Next-Generation Sequencing (NGS)-Gerät, das Nukleinsäuren-Sequenzierungen mit hoher Genauigkeit und relativ kurzer Laufzeit ermöglicht. Es wird häufig für Anwendungen wie Mikrobiom-Analysen, Amplikon-Sequenzierung und kleine Genomprojekte genutzt.
GridION
Das GridION von Oxford Nanopore ist ein NGS-Sequenziergerät, das Nanoporen-Technologie nutzt, um DNA- und RNA-Sequenzen in Echtzeit und ohne vorherige Amplifikation zu analysieren. Es eignet sich für eine breite Palette von Anwendungen, darunter Langsequenz-Reads und metagenomische Analysen.
Durchflusszytometer
Ein Laborgerät, das Partikel (meist Zellen) in einer Flüssigkeit durch Laserstrahlen leitet, um ihre physikalischen und chemischen Eigenschaften zu analysieren. Es ermöglicht das gleichzeitige Messen tausender Partikel pro Sekunde, was es ideal für Anwendungen in der Immunologie, Zellbiologie und Diagnostik macht.
Light Cycler
Dieses Gerät nutzt die quantitative, bzw. real-time PCR (qPCR) und dient der Vervielfältigung und quantitativen Messung von Nukleinsäuren in Echtzeit, die z.B. bei Genexpressionsanalysen und der Diagnose von Infektionen (siehe SARS-CoV2-Tests) verwendet wird. Mittels Fluoreszenz kann die DNA-Konzentration präzise während des Amplifikationsprozesses direkt gemessen werden, was so eine Quantifizierung ermöglicht.
Fluoreszenzmikroskop
Hier werden spezielle Fluoreszenzfarbstoffe anregt, um gezielt Strukturen in biologischen Proben sichtbar zu machen. Dies ermöglicht die hochauflösende Darstellung spezifischer Moleküle und Prozesse in Zellen und Geweben, was besonders in der Zellbiologie und auch der Mikrobiologie genutzt wird.
Microplate-Reader
Dieses Gerät misst die Absorption, Fluoreszenz oder Lumineszenz in einer Mikrotiterplatte, um chemische, biologische oder physikalische Eigenschaften von Proben zu analysieren. Es wird häufig in der Biotechnologie, Medizin und Pharmazie verwendet, etwa für Enzymtests, Protein- und Nukleinsäureanalysen. Bsp. ELISA (eine Methode zum Nachweis von Antikörpern oder Antigenen in einer Probe).
Ultrazentrifuge
Dieses Gerät erreicht im Gegensatz zu normalen Laborzentrifugen sehr hohe Rotationsgeschwindigkeiten (bis zu 150.000 UPM), um Partikel wie Makromoleküle oder Zellbestandteile aufgrund ihrer Dichte effizient zu trennen. Durch die starke Zentrifugalkraft können selbst winzige Unterschiede in der Masse oder Dichte von Partikeln analysiert und getrennt werden.
Forschung und Lehre als Einheit
Von Beginn an werden die Studierenden durch praktische Einheiten in wissenschaftliche Arbeitsweisen im Labor eingeführt und haben später die Möglichkeit, ihre Abschlussarbeiten dort zu erstellen.
Auch an den zahlreichen Publikationen der Arbeitsgruppen können sie mitwirken. Die Fakultät gehört zu den forschungsstärksten der Hochschule und ist international hervorragend positioniert.
Weiterführende Informationen
Neues aus der Forschung an der HFU
Laborleitung
wir informieren gerne rund ums Labor Molekulare Biomedizin